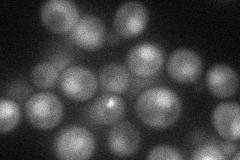
YGL071W
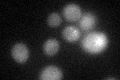
YGL071W

View description
Transcription factor involved in iron utilization and homeostasis; binds the consensus site PyPuCACCCPu and activates the expression of target genes in response to changes in iron availability
Localization:
Intensity:
Fold change:
Significance:
-
C’ GFP library in SD

below threshold17.15 -
N' NOP1pr-GFP in SD
cytosol,nucleus33.7444 -
N' TEF2pr-mCherry in SD

nucleus30.7148 -
N' NATIVEpr-GFP in SD

nucleus51.0549 -
N' TEF2pr-VC and Cyto-VN in SD

cytosol34.5802 -
C’ GFP library in SD+DTT
cytosol18.651.08No -
C’ GFP library in SD+H2O2

cytosol20.291.18No -
C’ GFP library in Starvation Media

cytosol14.530.84No -
C’ GFP library on the background of Pup2-DaMP

below threshold -
C’ GFP library on the background of CCT mutant

below threshold18.10511.05512No
